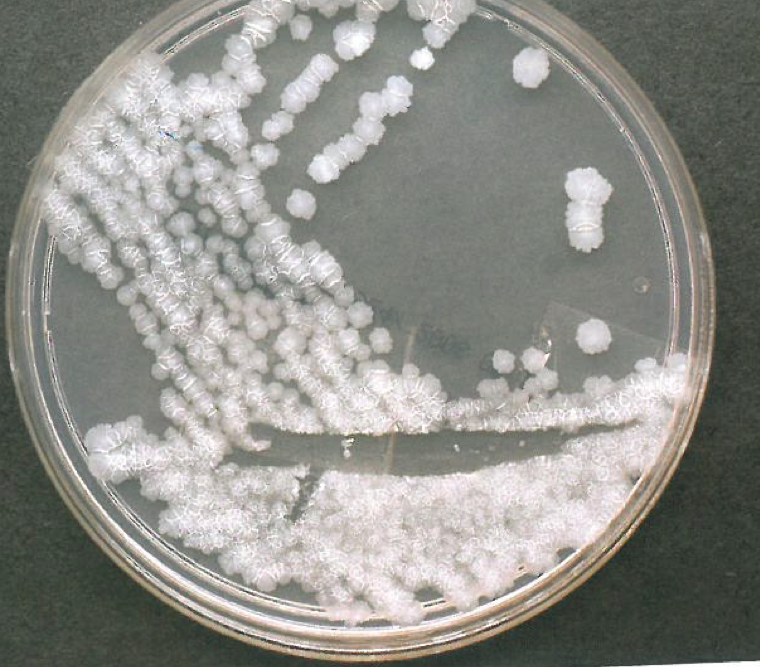
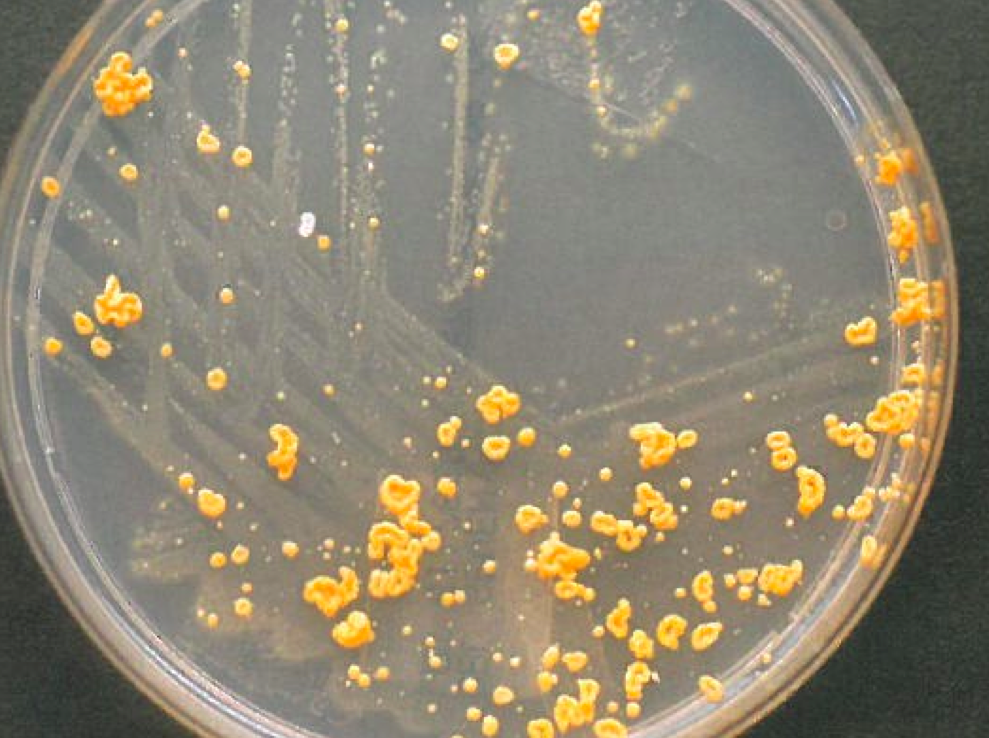
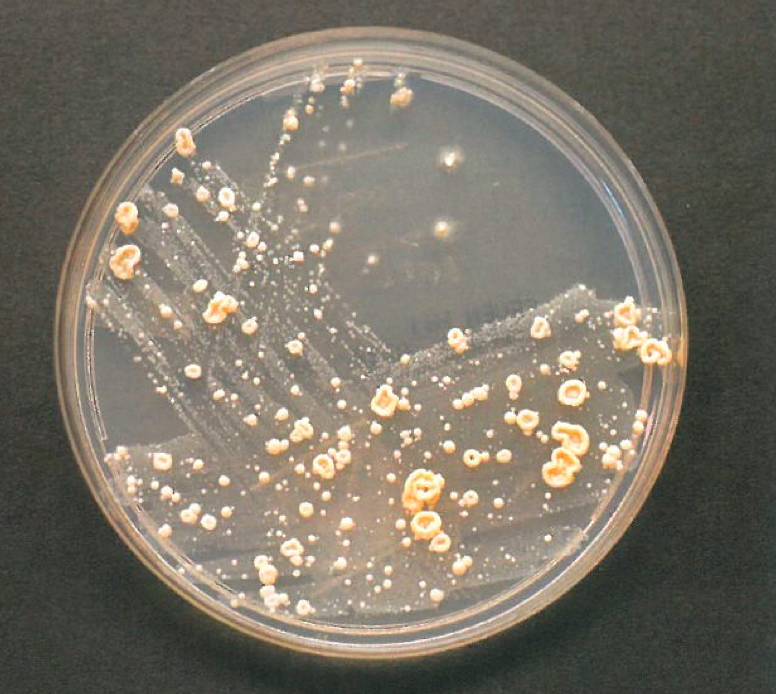
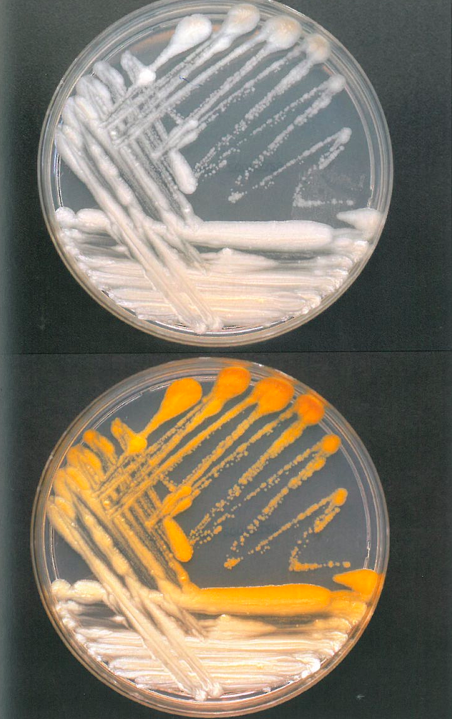

Direct examination of mycobacteria
Gram stain: typically invisible; gram+ rods ultrastructurally
Visible by acid-fast (Ziehl-Neelsen, Kinyoun) or by auramine rhodamine fluorochrome
Mycobacteria culture
Full identification of mycobacteria isolated in culture
Important Mycobacterial species in the lung
MAC, M TB, M kansasii, M xenopi, M abscessus
Important Mycobacterial species in the lymph node
MAC, M TB, M scrofulaceum, M haemophilum
Important Mycobacterial species in the skin and soft tissue
M fortuitum, M chelonae, M abscessus, M marinum, M ulcerans, M haemophilum
Important Mycobacterial species in GI tract
M TB, MAC
Mycobacterium tuberculosis
Adjunctive diagnostic tests for M tuberculosis
Nontuberculous mycobacteria
Isolation does not necessarily indicate infection
Mycobacterium avium complex
M kansasii
M marinum
Associated with wound exposure to fresh water fish tanks or salt water, and causes localized cutaneous infection (fishtank granuloma)
M ulcerans
indolent, necrotizing, ulcerating cutaneous lesions (Buruli ulcer)
M leprae